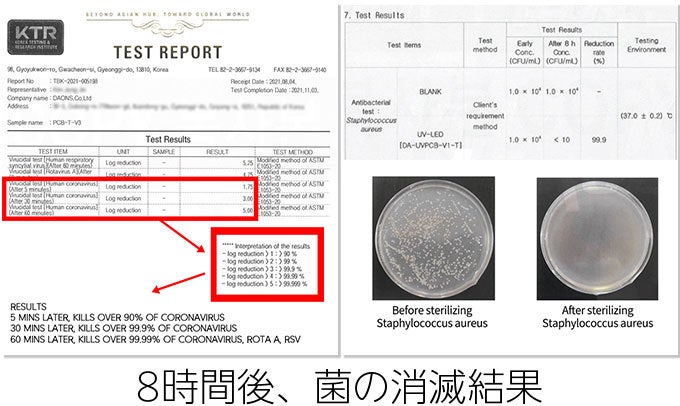

除菌ライトにも、照明にもなる!置く場所を選ばない、新しい時代の可視光線除菌【Therapy365V-1】の販売を開始しました。
UV-Cに代わる新しい時代の可視光線除菌システム。どんなものでも安全に除菌できます。
株式会社RINOCOCO(代表者:中矢大誠 岐阜県不破郡)は、2022年6月30日11時より、クラウドファンディングサービスMakuakeにて、「除菌ライトにも、照明にもなる!置く場所を選ばない、新しい時代の可視光線除菌【Therapy365V-1】」の販売を開始いたしました。

◆Therapy365V-1とは?
いままでは、UV除菌といえば、紫外線UV-Cでした。
しかしこれからの除菌は可視光線が主流です!
可視光線なら人体やペットに優しく、除菌する場所を選びません。

- UV-Cに代わる新しい時代の可視光線除菌。そのメリットを最大限に生かした除菌アイテム
- 人体に安全だから置く場所を選ばない。キッチン、玄関、子供部屋などのあらゆるものを除菌できる
- 緑色LEDの光は、ムーディーなルームライトにも。人感センサー搭載で近づくと白色灯に早変わり
◆家の中をしっかり除菌するには、Therapy365-V1が効果的です。
家の中には、あちこち菌が繁殖しています。スマホ、ドアノブ、台所のまな板、玄関の傘や靴、キーボードやお子様のおもちゃ。

Therapy365-V1なら
- 可視光線だから、人やペットにやさしい
- スイッチを入れるだけで除菌できる
使い方も簡単。Therapy 365-V1をつけたい場所に両面テープやネジでセットしたら、電源を入れるだけ。
LEDライトを照らしておくだけで、照射した物の除菌ができます。

- 洗えないものもしっかり除菌
革靴やベッドのまくら、子供のおもちゃやベビーチェアなど、洗いたくても洗えないもの、ありますよね。Therapy 365-V1なら、そんな洗濯機に入らないものも、照射してしっかり除菌できちゃいます。

- 人感センサーで白色ライトにも
動きが検出されると白色ライトが点灯するので、暗い部屋でもスイッチを探す必要がないのはうれしいですね。
白色ライトは30秒間点灯し続け、動きを検知しなくなると、自動的にUVモードに戻ります。

◆Therapy365-V1なら、除菌はもちろん夜間照明にも


◆取り付け方も簡単

◆商品概要
商品名:Therapy365-V1

- スイッチ:4種類(AUTOモード、白色点灯、UV除菌ON、電源オフ)
- 重さ:540g
- 大きさ:600mm x 55mm x 22mm
- 素材:
- ケース:アルミニウム
- 各カバー:ABS樹脂
- カバー:ポリカーボネイト
- 白色LED:15W 4000K、36チップ
- 入力:AC100-240VAC、50/60Hz、0.6A
- 出力:12V 1500mA
【販売セット】

- ライト本体
- アダプター1個
- ブラケット
- ケーブルホルダー6個
- 取付用のシリコン製両面テープ4個・木ねじ
- 取扱説明書(日本語)
【Makuake プロジェクト概要】
受付期間: 2022年 6月 30日(木)から2022年 7月 30日 (土)まで
目標金額: 100,000円
詳細URL :https://www.makuake.com/project/therapy365v-1/
■会社概要
屋号 :株式会社RINOCOCO
代表者 :中矢 大誠
所在地 :岐阜県不破郡垂井町2100-22
設立 :2021年8月
事業内容:卸売業者、小売業(EC・通販/卸売・問屋 )
HP :https://rinococo13.com/
すべての画像